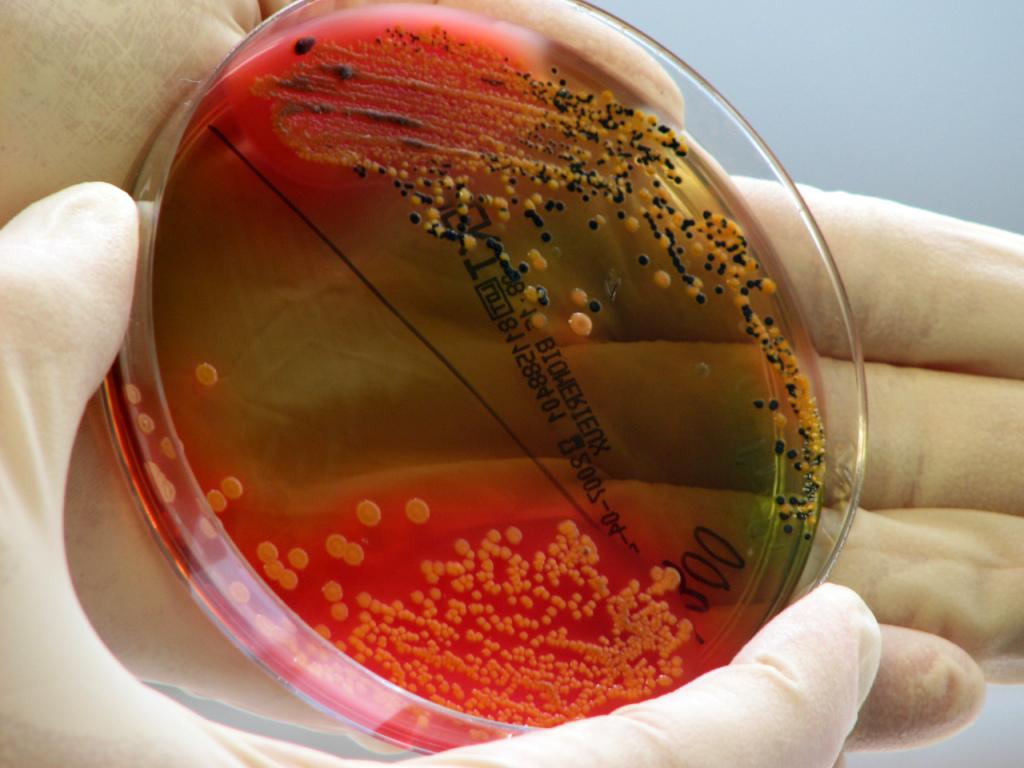

Troppa igiene favorisce lo sviluppo di batteri resistenti
(Keystone-ATS) Anche l’eccessiva igiene negli ospedali contribuisce alla diffusione di infezioni resistenti ai farmaci.
È quanto rivela uno studio pubblicato sulla rivista scientifica Nature Communications, che mette in luce come la diversità di batteri riduca lo sviluppo di ceppi resistenti.
Il numero di persone che si ammalano e muoiono a causa dei cosiddetti ‘super batteri’ è in aumento in tutto il mondo, e contrastarli è una delle più importanti sfide globali.
In questo contesto, il gruppo di ricerca guidato da Gabriele Berg, che dirige l’Istituto di biotecnologia ambientale presso l’Università di Tecnologia di Graz, in Austria, ha studiato come il grado di pulizia e le misure igieniche influenzino lo sviluppo delle resistenze.
I ricercatori hanno confrontato il microbioma e il ‘resistoma’, cioè tutti i microrganismi esistenti e i gruppi di geni di resistenza agli antibiotici, presso l’unità di terapia intensiva dell’Ospedale Universitario di Graz (ovvero un ambiente caratterizzato da forte controllo microbico) e in edifici pubblici e privati con minor controllo dell’igiene.
Le analisi mostrano che in aree con elevati livelli di igiene, la diversità microbica diminuisce e aumenta, di pari passo, la diffusione delle resistenze. La riduzione degli antibatterici utilizzati per le pulizie potrebbe migliorare la diversità microbica, ma il futuro potrebbe riservare anche soluzioni biotecnologiche pensate su misura per questo scopo.